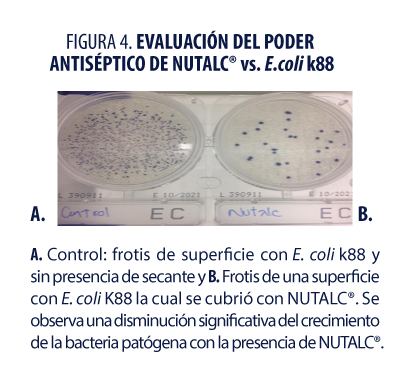

Secado de lechones al nacimiento: Una intervención para reducir el riesgo de mortalidad predestete
Edgar Olvera Vega, Myrna Olvera-García, Saúl Salgado, Gonzalo Villar y Alberto Casarín
DEPARTAMENTO TÉCNICO E INVESTIGACIÓN DE GRUPO NUTEC®
Los niveles de mortalidad antes del destete han aumentado en las unidades comerciales alrededor del mundo. Durante los últimos años promedian aproximadamente el 15% de los lechones nacidos vivos (PigChamp, 2019). Las estimaciones también sugieren que aproximadamente del 10 al 15% de los lechones nacidos son de bajo peso al nacer (es decir, pesan <1 kg) y que la mortalidad en estos lechones es extremadamente alta, a menudo superior al 50% (Vande Pol y Col., 2020). Se sabe que los lechones nacen con reservas de energía limitadas y si no son secados inmediatamente corren el riesgo de presentar hipotermia, por lo tanto, a partir de su nacimiento, los lechones, requieren de un rápido secado para reducir y evitar la mortalidad temprana (Blackie, N., 2019). El principal reto es que los lechones pasan de un ambiente cálido, como es el útero de la cerda (39 ºC), a un ambiente frío y húmedo como es la sala de parto (20-24 ºC), lo que provoca que durante los primeros 30 minutos de vida puedan perder de 3 a 5 ˚C de su temperatura corporal (Figura 1), y esto se complica aún más con el hecho de que presentan una casi inexistente capa de grasa subcutánea al nacimiento (Vande Pol y Col., 2020), siendo un hecho mucho más grave en lechones de bajo peso. Por lo tanto, es de suma importancia considerar la intervención de secado dentro de los procesos al recién nacido como estrategia potencial para reducir el grado de disminución de su temperatura (Vande Pol y Col., 2020), se minimiza la pérdida de calor asociada a la evaporación de fluidos amnióticos de la superficie corporal (Figura 1). Sin embargo, la efectividad puede variar dependiendo sobre todo del material para secado utilizado. Este proceso, en general, toma entre 20 a 30 segundos y su impacto representa un beneficio muy grande para los lechones.



Otro factor muy importante para considerar es la rápida depleción de las reservas de glucógeno y su relativa inmadurez metabólica, lo que los hace muy vulnerables en términos de termorregulación (Farmer C. y Edwards, S., 2020; Vande Pol y Col., 2020). Además, la hipotermia es una de las principales limitantes para la ingesta de calostro de calidad, ya que el lechón debe de estar activo para ir en busca de la ubre. El calostro resulta ser uno de los componentes más importantes que influyen en la supervivencia del lechón recién nacido (Tenbergen, R. y Metzenger, E., 2018), ya que provee el 75% de la energía que se requiere en las primeras 24 horas de vida (Farmer C. y Edwards, S., 2020). En promedio un lechón requiere de 29 minutos desde su nacimiento hasta que alcanza la ubre de su madre para comenzar con su ingesta de calostro. Como podemos observar en la figura 2, los lechones que llegan a la ubre dentro de los primeros 30 minutos de vida logran estar hasta 3.9°C más calientes que los que tardan más de 90 minutos en encontrarla (Tenbergen, R. y Metzenger, E., 2018). Lo anterior resalta la importancia del secado en los lechones, el cual los ayuda a mantener su temperatura corporal y con ello promover una rápida ingesta de calostro.

En general se consideran como principales métodos de secado el uso de toallas de papel, toallas de tela, paja, así como el uso de talcos secantes, complementado con la ubicación de los lechones bajo una lámpara como fuente de calor (Blackie, N., 2019).
Los secantes en talco son productos que tienen la capacidad de absorber y retener agua, promoviendo la reducción de humedad en superficies y en la piel del lechón. La capacidad de absorción se define como el cociente entre el peso de agua que absorbe el secante y su propio peso cuando está seco, es decir; cuánta agua es capaz de absorber hasta el punto de saturación por unidad de peso (Zambrano-Zaragoza M. y Col., 2003). En el mercado se estipula que un talco secante debe demostrar tener al menos una capacidad absorbente >1.5 veces su peso, para garantizar un buen rendimiento. Sin embargo, este debe de cumplir con otras características físicas como son: 1) Capacidad de retención de agua, tiempo que es capaz de mantener atrapada el agua que se absorbió y 2) Capacidad de dispersarse y/o aplicarse de forma homogénea, con el fin de que se garantice la cobertura total de la superficie, lo cual va a estar relacionado con el tamaño de partícula del producto.
En el pasado los secantes se habían formulado pensando sólo en secar y su composición podía ser a base de diferentes materiales, como son: arcillas, minerales, óxidos, zeolita, bentonita cálcica, montmorillonita, aluminosilicatos, fibras vegetales, etc. Sin embargo, hoy en día se busca obtener más atributos en un producto secante, donde se pueden destacar: capacidad astringente (favorecer la captura de temperatura-efecto aislante), actividad antimicrobiana o antiséptico, neutralizador de amoniaco, promotor de cicatrización, etc. Hoy en día, el uso de los aceites esenciales y/o extractos de plantas han recobrado gran importancia debido a sus múltiples actividades biológicas benéficas para los animales, ya que los convierte en una gran herramienta para proveer de mejores características a un producto como lo es un secante, más allá de su atributo más conocido que es la mejora de las propiedades sensoriales (aroma). Por último, la composición de un secante debe garantizar la ausencia de compuestos que puedan ser irritantes a la piel del lechón y del operario que hará su aplicación.
En conclusión, el proceso de secado de lechones es mucho más que sólo retirar los líquidos de su cuerpo; es una etapa clave, donde el manejo adecuado de los mismos y el uso de un buen secante se verá reflejado en la disminución de la morbilidad que podría estar afectando su eficiencia productiva y en caso extremo incrementando la tasa de mortalidad.

Por lo tanto, en GRUPO NUTEC® mediante la investigación se ha desarrollado y mejorado una herramienta para el secado de los lechones a través del uso de un talco activador con alto poder secante y antimicrobiano; NUTALC® el cual es una mezcla de materias primas de origen mineral y fibras vegetales, otorgando los siguientes beneficios:
- Excelente capacidad de absorción provocando un secado rápido y uniforme (Figura 3).
- Rinde 9 % más que otros talcos secantes (Cuadro 1).
- Rápida activación de los lechones favoreciendo a su vitalidad. Los lechones toman calostro a los 21 minutos después de su secado (Cuadro 1).
- Potencial antiséptico que reduce la carga bacteriana (Figura 4).
- Amigable con el operario y el lechón (Figura 5).
- Favorece a la cicatrización de ombligos y minimiza la entrada de microorganismos patógenos.
- Mantiene la temperatura corporal del lechón, protegiéndolo de hipotermia.
- Aroma agradable (Figura 5).

En GRUPO NUTEC® innovamos y mejoramos nuestros productos mediante investigación in vitro (Laboratorio BSL2) e in vivo (Granja experimental iiia).
Referencias:
- Blackie N, 2019. In newborn piglets does drying versus no intervention reduce the risk of mortality pre-weaning?. Veterinary Evidence, vol. 4, no 4.
- Farmer C y Edwards SA, 2020. The neonatal pig: developmental influences on vitality." The suckling and weaned piglet. Wageningen Academic Publishers. 649-653.
- Morales J, Manso A, Aparicio M, Piñeiro C, 2010. Use of a new technology based on thermography to monitor health and risk factors in newborn piglets. Proceedings of the IPVS Meeting, Vancouver. pp.1182.
- PigChamp. 2017, 2018, 2019. Benchmarking summaries. www.pigchamp.com/benchmarking (Accessed January 14, 2021).
- Tenbergen R y Metzger E, 2018. Early pig care: off to the races. London swine conference. Pp 89-101.
- Vande Pol KD, Tolosa AF, Shull CM, Brown CB, Alencar SAS, Ellis M, 2020. Effect of method of drying piglets at birth on rectal temperature over the first 24 h after birth, Translational Animal Science, Volume 4, Issue 4.
- Zambrano-Zaragoza ML, Gallardo-Navarro YT, Meléndez RP, Arjona-Román JL., 2003. Metodología de superficie de respuesta aplicada a la optimización de la capacidad de hidratación y extruido de cascarilla de maíz con base en avena. Información tecnológica. Vol 14, pp.38
Contacto:
Contacta con nosotros a través del siguiente formulario.
